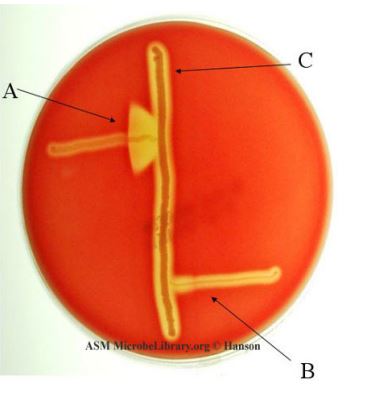
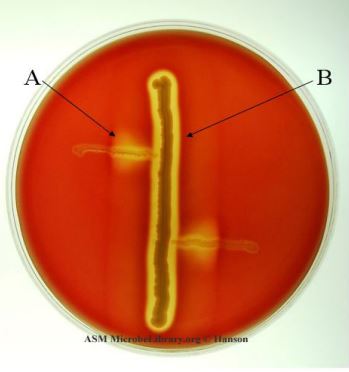
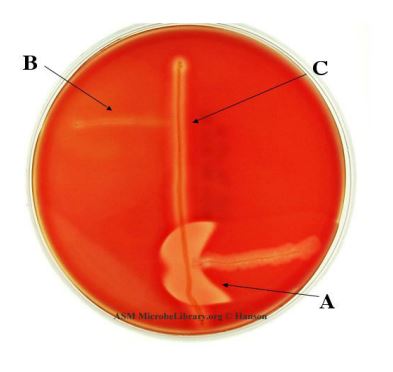
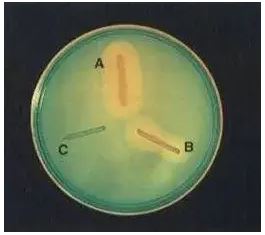

Asetat Kullanımı
I.-Prensip
Asetat agar mikroorganizmaların asetatı kullanıp kullanmadıklarını test etmek amacıyla kullanılan bir besiyeridir. Besiyeri içinde bulunan sodyum asetat mikroorganizmalara tek karbon kaynağını, inorganik amonyum tuzları ise nitrojen kaynağını sağlar. Bakteri asetatı kullandığında amonyum tuzlarından oluşan amonyak ortamın alkali olmasına neden olur. Besiyeri içinde bulunan bromthymol blue (pH indikatörü) renk değiştirerek besiyerinin yeşilden maviye dönmesini sağlar. Bu test özellikle E.coli ile Shigella türleri arasında ayırım yapmak için kullanılmaktadır. E.coli suşlarının yaklaşık %84’ü asetatı kullanırken, Shigella türlerinin büyük bir kısmı asetatı kullanmamaktadır.
II.-Besiyerleri ve Ayıraçlar
| Besiyeri | |
| Sodium chloride | 5 g |
| Magnesium sulfate | 0,1 g |
| Ammonium phosphate monobasic | 1 g |
| Potassium phosphate diphasic | 1 g |
| Sodium acetate | 2 g |
| Agar | 20 g |
| Bromthymol blue | 0,08 g |
| Distile su | 1 L |
Besiyeri tüplerde yatık olarak hazırlanır. pH’sı 6.7’ye ayarlanır.
III.-Kalite Kontrol
A- Pozitif kontrol: E.coli ATCC 25922
B-Negatif kontrol: Shigella flexneri ATCC 12022
IV.-Yöntem
Test edilecek bakterinin taze ve saf kültüründen bir koloni alınarak besiyerinin yatık kısmına ekim yapılır. Tüpler Enterobacteriaceae ailesi için 5 gün 35-37ºC’de, non-fermenter bakteriler için 7 gün 30ºC’de inkübe edilir.
V.-Sonuçların Değerlendirilmesi
Besiyerinin yatık kısmında üremenin olması ve yeşil rengin maviye dönmesi testin “pozitif” olduğunu göstermektedir. Aksine besiyerinin yatık kısmında üremenin olmaması ve rengin yeşil olarak kalması testin “negatif” olduğunu gösterir.
CAMP Testi
I.-Prensip
CAMP testi, grup B Streptokok olan Streptococcus agalactiae‘yi grup A streptokok olan Streptococcus pyogenes‘ten ve diğer Streptokoklardan ayırt etmek için kullanılır.
Bilindiği gibi Staphylococcus aureus β-hemolitik olup β-lizin üretirler. Üretilen β-lizin, Streptococcus agalactiae tarafından üretilen CAMP faktörüyle sinerjik ilişkiye girerler. CAMP faktörü Streptococcus agalactiae‘nın hemolitik olan ve olmayan suşları tarafından üretilir. Sinerjik reaksiyon, bu iki bakterinin ekim hatları arasında belirgin hemoliz olarak kendisini gösterir. Sinerjik bölge, grup A, C ve G Streptokoklarda görülmez.
II.-Besiyerleri ve Ayıraçlar
CAMP testi için koyun kanlı agar kullanılır.
III.-Kalite Kontrol
A.-Pozitif Kontrol :Streptococcus agactiae
B.-Negatif Kontrol :Streptococcus pyogenes
IV.-Yöntem
β-toksin ürettiği bilinen Staphylococcus aureus, bir öze ile koyun kanlı agarın ortasından bir hat halinde ekilir. Grup B Stretokok olduğu düşünülen test edilecek bakteri suşu bu hatta dik olacak şekilde ekilir. Test bakterileri, S. aureus çizgisine 2 mm mesafede olmalı ancak ona dokunmamalıdır. Petri kutuları 35°C’de 24 saat inkübe edilir.
V.-Sonuçların Değerlendirilmesi
(A) Streptococcus agactiae, (B)Streptococcus pyogenes, (C) Staphylococcus aureus
CAMP pozitif bir sonuç, S.aureus ve test bakterisi arasındaki alanda “ok ucu” şeklinde β-hemoliz bölgesi olarak görülür. CAMP negatif sonuçta ise böyle artmış bir β-hemoliz bölgesi gözlenmez.
(A) Listeria monocytogenes, (B) Staphylococcus aureus
Listeria monocytogenes‘i tanımlamak için CAMP testi kullanılmaktadır. L. monocytogenes, koyun kanlı agar plakasında β-hemolitik Staphylococcus aureus çizgisine dik açıyla aynen Streptococus agactiae gibi dik olarak ekilir. Ekilen petri kutuları 35°C’de 24 saat inkübe edilir. Pozitif bir CAMP reaksiyonu, daha zayıf bir gelişmiş β hemoliz bölgesi ve daha küçük, daha az belirgin dikdörtgen bir hemoliz bölgesi ile gösterilir.
(A) Clostridium perfiringens, (B)Clostridium septicum, (C) Streptococcus agactiae
Ters CAMP testi Clostridium perfringens’in bir koyun kanlı agar plakasının ortasından aşağı doğru ekilmesiyle yapılır. Streptococcus agalactiae , Clostridium perfringens’e dik açıyla ekilir. Ekim hatları birbirine değmez ancak 1 ila 2 mm kalana kadar yaklaşır. Ekilen petriler anaerobik olarak inkübe edilir. Pozitif bir ters CAMP, Clostridium perfringens ve Streptococcus agalactiae ekim hatları arasında ok şeklinde bir hemoliz bölgesiyle sonuçlanır
DNaz Testi
I.-Prensip
DNaz, DNA’yı hidroliz ederek serbest nükleotitlerin ve fosfatın ortaya çıkmasını sağlayan bir enzimdir. Bu enzimi saptamaya yönelik indikatör içeren ya da içermeyen bir çok besiyeri kullanılabilmektedir. Geliştirilen ilk besiyerinde indikatör bulunmamakta ve DNA’nın hidroliz olduğuna dair tanı, agar üzerine eklenen HCl varlığında besiyerinin berrak hale gelmesinin gözlenmesi ile konmaktadır. HCl varlığında oligonükleotitler çözünürken, DNA tuzları çözünmeden kalmaktadır. İndikatör olarak methyl gren eklendiğinde DNA indikatörle bağlanarak yeşil renk oluşmakta, DNA hidroliz olduğunda methyl green serbestleşerek renksiz hale gelmektedir. İndikatör olarak toluidine blue O eklendiğinde ise hidroliz sonunda besiyeri rengi pembeye dönüşmektedir. İndikatörün eklenmesi bazı bakteriler için inhibitör etki gösterebilmektedir. Bu sorun, yoğun inokulum kullanılarak aşılmaktadır.
II.-Besiyerleri ve Ayıraçlar
Bu amaçla esculin agar veya esculin buyyon kullanılabilir.
| DNaz Test Besiyeri | |
| Deoksiribonükleik asit | 2 g |
| Phytone | 2 g |
| Trypticase | 15 g |
| Sodyum klorür | 5 g |
| Agar | 15 g |
| Distile Su | 1 g |
| Besiyeri pH 7,3 +/- 0,2 olarak ayarlanır. | |
| Ayıraçlar | |
| 1.1 N HCl | 5 L |
| HCl | 2,8 mL |
| Distile su | 97,2 mL |
| 2.methyl green boyası | 100 mg |
Ayıraç olarak boya kullanılacak ise1 L besiyerine 100 mg konulur ve besiyerleri dökülür.
III.-Kalite Kontrol
A- Pozitif kontrol: M. catarrhalis ATCC 25240/Serratia marcescens ATCC 13880/S. aureus ATCC 25923
B- Negatif kontrol: Escherichia coli ATCC 25922
IV.-Yöntem
İncelenecek bakterinin saf ve taze kültüründen yoğun bir inokulum alınarak DNaz test besiyerinin ortasına çizilerek ekilir. DNaz enzimi düşük sıcaklıkta aktif olduğu için petri kutuları oda ısısında (22-25ºC) 24-72 saat inkübe edilir.
V.-Sonuçların Değerlendirilmesi

1. İndikatör olarak HCl kullanılacaksa inkübasyon süresi sonunda Plak yüzeyini kaplayacak şekilde besiyeri üzerine HCl eklenir. HCl, DNA ile birleştiğinde presipite olarak mat bir görüntü oluşturur. Bu nedenle bakteride DNaz enzimi varsa ekim çizgisi çevresindeki DNA’yı parçalayacağından tüm besiyeri alanları mat görünüş verirken, ekim çizgisinin etrafında saydam bir görüntü oluşur ve test “pozitif” olarak değerlendirilir.
2. İndikatör olarak methyl green kullanılmışsa inkübasyon sonunda ekim çizgisinin etrafında besiyeri renginin açıldığı ve berrak bir görüntü oluştuğu gözlenir ve test “pozitif” kabul edilir. DNaz enzimi yok ise besiyeri yeşil rengini korur ve sonuç “negatif” olarak rapor edilir.
3.-Diğer DNaz Pozitif Bakteriler
Campylobacter jejuni
Corynebacterium diphtheriae
Eskülin Hidrolizi
I.-Prensip
Esculin bazı bakteriler tarafından hidroliz edilerek glikoz ve eskuletine parçalanır. Oluşan eskuletin besiyerinde bulunan ferrik iyonlar ile birleşerek siyah renkte bir bileşik oluşturur. Hidroliz olmayan eskulin 360 nm UV ışığında floresan vermektedir. Hidroliz olduğu zaman floresan verme özelliği kaybolarak siyah renge dönüşür.
II.-Besiyerleri ve Ayıraçlar
Bu amaçla esculin agar veya esculin buyyon kullanılabilir.
| Esculin agar | |
| Pepton | 5 g |
| Ferric sitrat | 0,5 g |
| Dipotasyum fosfat | 1 g |
| Eskülin | 3 g |
| Andrade indikatörü | 10 mL |
| Distile su | 1 L |
Maddeler eriyinceye kadar ısıtılır. Daha sonra 55ºC’ye kadar soğutularak pH 7.0 4/- 0.2’ye ayarlanır. Tüplere 5’er ml dağıtılan besi yeri otoklavlanarak steril edilir. Yatık olarak soğutulur.
III.-Kalite Kontrol
A- Pozitif kontrol:Aeromonas hydrophila ATCC 7965
B- Negatif kontrol: Pseudomonas aeruginosa ATCC 27853
IV.-Yöntem
Test edilecek bakterinin taze ve saf kültüründen 1 koloni alınarak ya esculin agarın yüzeyine ya da esculin buyyona ekimi yapılarak 18-24 saat 35ºC’de inkübe edilir.
V.-Sonuçların Değerlendirilmesi

Eskülin hidrolizi sonucunda oluşan eskületin besi yerinde bulunan demir sitrat ile birleşerek siyah bir bileşik oluşturur. Ya da hidroliz öncesi floresan veren eskülin hidrolize olduğu zaman bu özelliğini kaybeder. İnkübasyon sonunda siyah rengin gözlenmesi ya da floresan özelliğinin gözlenmemesi bakterinin eskülini hidrolize ettiği anlamını taşır. Bu durumda test “pozitif” olarak değerlendirilir. Siyah rengin oluşmaması veya floresan özelliğinin kaybolmaması eskülinin hidroliz edilmediği anlamına gelir. Bu koşulda test “negatif” olarak değerlendirilir
Fenilalanin Deaminaz Testi
I.-Prensip
Feniaalanin deaminasyon sonucu fenilpirüvik aside dönüşen bir aminoasittir. Enterobacteriaceae ailesi içinde sadece Proteus, Morganella ve Providencia cinsi bu dönüşümü sağlayacak deaminasyon enzimine sahiptir. Fenialanin deaminasyon testi, deaminasyon sonucu oluşan pirüvik asidi saptamaya yönelik bir testtir.
II.-Besiyerleri ve Ayıraçlar
Fenilalanin agar tüplerde yatık olarak hazırlanır. Besiyeri içinde bulunan maya ekstresi, karbon ve nitrojen kaynağını karşılamaktadır. Et ekstresi ve protein hidrolizatlar içerdikleri doğal fenilalanin nedeniyle besiyerinde kullanılmamaktadır.
| Besiyeri | |
| DL-Phenylalanine | 2 g |
| Maya ekstresi | 3 g |
| Sodyum klorür | 5 g |
| Disodyumfosfat | 1 g |
| Agar | 12 g |
| Distile Su | 1 L |
| Ayıraçlar | |
| Ferrik klorür | 12 g |
| Konsatre HCl | 2,5 mL |
| Distile su | 100 mL |
Besiyerinin pH’sı 7,3′ e ayarlanır.
A- Pozitif kontrol: Proteus türleri
B- Negatif kontrol: Escherichia coli ATCC 25922
IV.-Yöntem
Besiyerinin yatık yüzeyine test edilecek mikroorganizmanın taze ve saf kültüründen bir koloni alınarak ekim yapılır. Onsekiz ila yirmidört saat 35ºC’de inkübe edilir. İnkübasyonu takiben besiyeri yüzeyine 4-5 damla ayıraç damlatılır ve bütün yüzeyle temas etmesi sağlanır.
V.-Sonuçların Değerlendirilmesi

Yüzeyde oluşan yeşil renk piruvik asit oluşumunu göstermektedir ve test “pozitif” olarak değerlendirilir. Renk değişiminin görülmediği koşulda deaminasyonun gerçekleşmediği sonucuna varılarak test “negatif” olarak değerlendirilir.
KARBONHİDRAT FERMENTASYON TESTLERİ
I.-Prensip
“Fermantasyon” ifadesi genellikle karbonhidratların anaerobik koşullarda parçalanması için kullanılır. Fakültatif anaerobik bakteriler kolaylıkla karbonhidratları fermente ederler. Sıklıkla karbonhidrat denildiği zaman bir şeker akla gelir. Ancak karbonhidratlar içerisinde bazı kimyasal bileşiklerin yapısını açıklamak için şeker ifadesini kullanmak uygun olmaz. Buna örnek olarak dulsitol ve mannitol verilebilir. Karbonhidrat fermantasyon testleri, mikroorganizmaların karbonhidratları fermente etmesini göstermek üzerine kuruludur. Bakterilerin türleri hatta suşları karbonhidrat fermentasyonu açısından farklılıklar gösterir. Fermantasyonda son elektron alıcısı olarak organik bir bileşik görev yapar. Fermentasyon sonucunda bir asit veya asitle birlikte gaz oluşur. Ortaya çıkan son ürün fermente edilen substrata, enzimlere, pH ve ısı gibi faktörlere bağlı olarak değişir. Bakteriyel fermantasyon sonucu sıklıkla ortaya çıkan ürünler olarak laktik asit, formik asit, asetik asit, bütirik asit, bütil alkol, aseton, etil alkol, karbondioksit ve hidrojen sayılabilir. Fermantasyon reaksiyonları sonucu ortaya çıkan asit ürünler ortamın pH değerini değiştirir. Bu değişiklik bir renk indikatörü kullanılarak göz ile görülebilir hale getirilebilir. Bunun için bir pH indikatörü ve tek bir karbonhidrat içeren besiyeri kullanılır. Fakat bakterilerin ortamdaki peptonları da kullanarak alkali yan ürünler ortaya çıkardığı, pH değerinin sadece karbonhidrat fermantasyonu sonucu aşırı yeterince asit üretildiğinde değiştiği unutulmamalıdır.
II.-Besiyerleri ve Ayıraçlar
Karbonhidrat Fermentasyon Testlerinde Kullanılabilecek Başlıca İndikatörler
| Normal pH | Normal Renk | Pozitif pH | Pozitif Renk | Negatif pH | Negatif Renk | |
| Andrade’s | 7,1-7,2 | Pembe | 5 | Koyu pembe | 12-114 | Sarı, renksiz |
| Bromocresol purple | 7,4 | Koyu Mor | 5,2 | Sarı | 6,8 | Mor |
| Bromothymol blue | 7 | Yeşil | 6 | Sarı | 7,6 | Prusya mavisi |
| Phenol red | 7,4 | Kırmızı-Turuncu | 6,8 | Sarı | 8,4 | Pembe kırmızı |
| Fermentasyon Besiyeri | |
| Trypticase veya proteose peptone no. 3 | 10 g |
| Sodyum klorür | 5 g |
| Et ekstresi | 1 g |
| Phenol red | 0,018 g |
| Distile su | 1 L |
| Karbonhidrat* | 10 g |
| Besiyerinin pH değeri 7,4 ± 0,2 olmalıdır. | |
| *Sadece otoklav ile steril edilecekse toz halinde kullanılır. |
Karbonhidratların sterilizasyonu otoklav veya filtre kullanılabilir.
1.-Tüm besiyerini otoklav kullanarak steril etme:
Kullanılacak toz halindeki besiyeri malzemeleri 1 litre distile su içinde yavaş yavaş ısıtılarak eritilir. Daha sonra pH indikatörü olan fenol kırmızısı eklenir. Hazırlanan besiyerinin son pH değeri 7,4 ± 0,2 olacak şekilde ayarlanır. Hazırlanan sıvı besiyeri 13X100 mm ebatındaki tüplere 4-5 mL hacımda dağıtılır. İçlerine Durham tüpleri ters olarak konulur. Hazırlanan tüplerdeki besiyerleri otoklavlarda 116 ila 118°C’de 15 dakika tutularak sterilize edilir.
Arabinoz, laktoz, maltoz, salisin, sükroz, trehaloz ve ksiloz uzun süre ısı altında parçalandığından sadece 121°C’de 3 dakika tutulur.
Hazırlanan besiyerleri 4 ila 10°C’de 6-8 hafta saklanabilir.
2.-Besiyerini otoklav ile karbonhidratları filtre kullanarak steril etme:
Karbonhidrat hariç tüm malzemeleri 800 ml distile su içinde hazırlanır. Isıtılarak ve karıştırarak iyice erimesi sağlanır. Son pH değeri 7,4 ± 0,2 olmalıdır. Hazırlanan besiyeri 13 x 100 mm’lik tüplere 4,5 mL hacmında dağıtılır. Gaz üretimini tespit etmek için ters çevrilmiş bir Durham tüpü yerleştirilir. Tüpler 121°C’de 15 dakika otoklavlayarak sterilize edilir. Otoklavdan çıktıktan sonra 42 ila 50°C’lik bir su banyosunda soğutulur.
Test edilecek karbonhidrat 10 gram tartılarak 200 mL distile su içine eklenir. Hazırlanan solüsyon 0,45 µm gözenek boyutuna sahip membran filtreden geçirilir.
Su banyosunda soğutulmuş olan tüplerin her birisine 0,5 mL karbonhidrat içeren solüsyondan eklenir. Son pH değeri 7,4 ± 0,2 olmalıdır.
Hazırlanan besiyerleri 4 ila 10°C’de 6-8 hafta saklanabilir.
Fermentasyon sonucu gaz oluşumu Durham tüpleri ile saptanır. Durham tüpleri kullanılan fermentasyon tüplerinden daha küçük çaplı tüplerdir. Örneğin 13-15X100 mm tüp kulanılıyor ise bu tüplerin içine 5-6X50 mm ebatlarında tüpler kullanılır. Tüpler ters olarak konulur. Normal koşularda içinde besiyeri olan Durham tüpleri gaz oluşumunda kabarcıklar içerir.
III.-Kalite Kontrol
| Karbonhidrat | Pozitif Kontrol | Negatif Kontrol |
| Adonitol | Enterobacter aerogenes ATCC 13048 | Escherichia coli ATCC 25922 |
| L-arabinoz | Enterobacter aerogenes ATCC 13048 | Serratia marcescens ATCC 13880 |
| Sellobiyoz | Enterobacter cloacae ATCC 13047 | Morgenella morganii ATCC 8019 |
| Dulsitol | Escherichia coli ATCC 25922 | Morgenella morganii ATCC 8019 |
| Gliserol | Enterobacter aerogenes ATCC 13048 | Shigella flexneri ATCC 9199 |
| Myo-inositol | Enterobacter aerogenes ATCC 13048 | Shigella flexneri ATCC 9199 |
| Laktoz | Enterobacter cloacae ATCC 13047 | Morgenella morganii ATCC 8019 |
| Maltoz | Escherichia coli ATCC 25922 | Morgenella morganii ATCC 8019 |
| D-mannitol | Enterobacter aerogenes ATCC 13048 | Morgenella morganii ATCC 8019 |
| Rafinoz | Enterobacter aerogenes ATCC 13048 | Serratia marcescens ATCC 13880 |
| L-ramnoz | Enterobacter cloacae ATCC 13047 | Serratia marcescens ATCC 13880 |
| Salisin | Enterobacter aerogenes ATCC 13048 | Shigella flexneri ATCC 9199 |
| D-sorbitol | Escherichia coli ATCC 25922 | Morgenella morganii ATCC 8019 |
| Sukroz | Enterobacter cloacae ATCC 13047 | Morgenella morganii ATCC 8019 |
| Trehaloz | Escherichia coli ATCC 25922 | Morgenella morganii ATCC 8019 |
| D-ksiloz | Escherichia coli ATCC 25922 | Morgenella morganii ATCC 8019 |
| D-glikoz | Escherichia coli ATCC 25922 | Pseudomonas aeruginosa ATCC 27853 |
| Eritritol | Providencia rettgeri ATCC 29944 | Escherichia coli ATCC 25922 |
| D-melibiyoz | Enterobacter aerogenes ATCC 13048 | Morgenella morganii ATCC 8019 |
| D-mannoz | Enterobacter cloacae ATCC 13047 | Proteus vulgaris ATCC 8427 |
| D-arabitol | Enterobacter aerogenes ATCC 13048 | Morgenella morganii ATCC 8019 |
| Alfa-methyl-D-glucoside | Enterobacter aerogenes ATCC 13048 | Escherichia coli ATCC 25922 |
IV.-Yöntem
Test edilecek bakterinin saf ve taze kültüründen 1-2 koloni alınarak karbonhidrat fermentasyon besiyerine ekim yapılır. Tüpler 24 saat 35ºC’de inkübe edilir.
V.-Sonuçların Değerlendirilmesi

Phenol red kullanılmış fermentasyon tüpleri

Bromocresol purple kullanılmış fermentasyon tüpleri
İnkübasyon dönemi sonunda karbonhidrat fermentasyonu gerçekleşmişse, reaksiyon sonucu oluşan asitler nedeniyle ortam pH’sı asidik hale gelir. pH indikatörü renk değiştirerek besi yerinin sarıya dönmesini sağlar. Bu durumda test “pozitif” olarak değerlendirilir. Karbonhidratın fermente edilmemesi durumunda ise besi yeri pH’sında bir değişim olmayacağı için besi yeri rengi aynı kalır. Bu durumda test “negatif” olarak değerlendirilir.
2.Durham tüpünde kabarcık varlığı gaz oluşumu kabul edilir. Sarı renk oluşmadan gaz kabarcığı var ise test geçersizdir.
3.-Karbanhidrat fermentasyon testlerinde karbonhidratların %0.5-1 konsantrasyonları kullanılabilir. Reaksiyonun geri dönme olasılığını engellemek için %1 konsantrasyon tercih edilmelidir.
4.-Farklıbakteriler için tuz ilavesi ve serum ilavesi gerekebilir.

